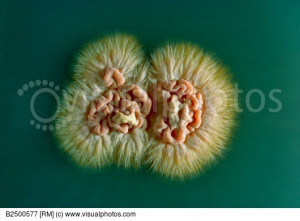
Funny Quotes Contact Us DMCA Notice

Fungus Quotes
Even as global warming increases the frequency of El Nino and the Atlantic event, their effects are being amplified by the annual loss of an area of rain forest the size of New Jersey. Less rain falls, and the water runs into the rivers instead of being sucked up by the fungus filaments and tree roots.